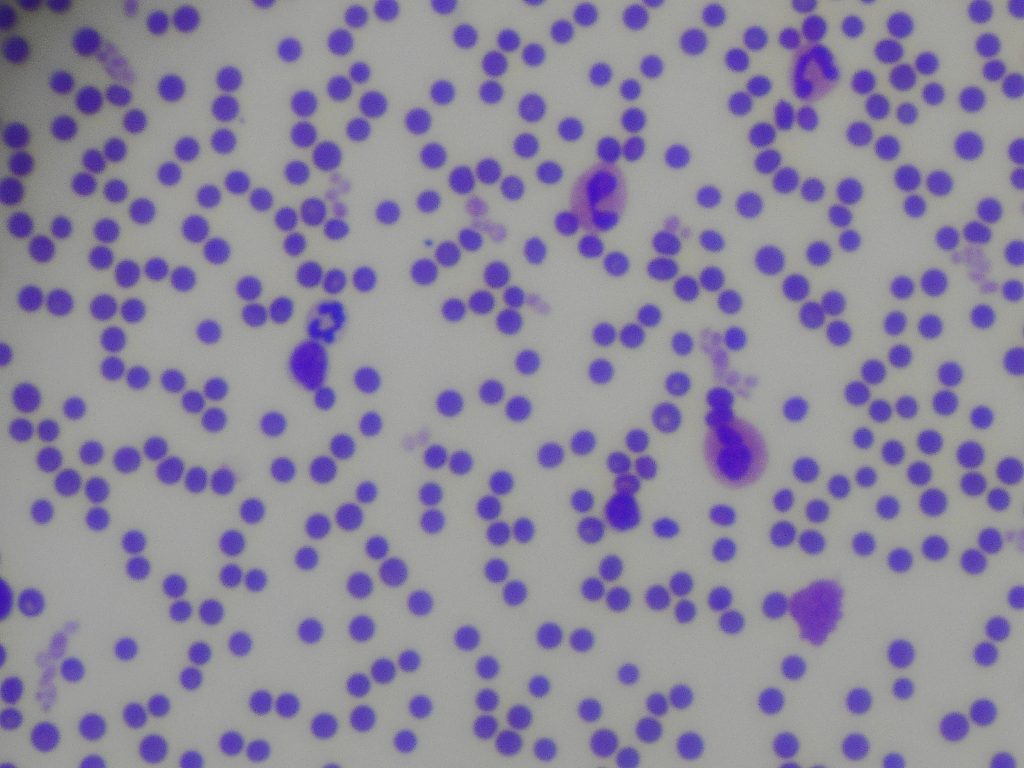
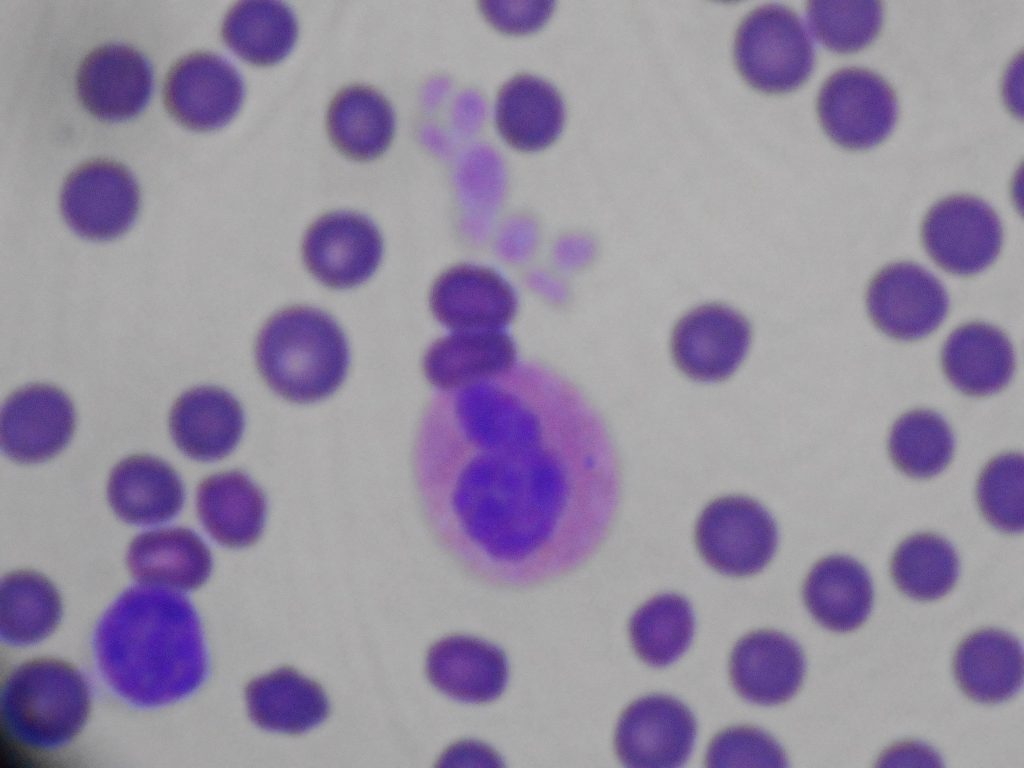

掻きむしって出血してるので爪切りを、という主訴です
抱き上げて診ると、全身

全身かゆいようです

背中側もヤバい
暫定診断:粟粒性皮膚炎
血液塗抹検査実施で、
診断:好酸球性皮膚炎
ちなみにこれが好酸球
スゴイ出てますよね、好酸球
この好酸球が増える主な病気が
①寄生虫疾患
②好酸球性皮膚炎
③ある種の腫瘍
もちろんノミダニの外部寄生虫と内部寄生虫の駆除薬処方
思い当たるのをつぶしていきます
②の治療はアレルギー疾患の仲間ですから抗ヒスタミン剤とステロイドを処方
劇的に治癒するはずです
待ちましょう
・・・・・好酸球ってどれ?っというお声が聞こえてきそうですね
このピンク色した細胞質を持つ細胞が好酸球
アレルギーを中和してくれる細胞です
詳しく知りたい方はかかりつけ医にも、お問い合わせください
当院では血液検査の内臓だけではなく、
血液塗抹での診断もしております

したっけ
オークyoutube
 we call Feline Miliary Dermatitis.
we call Feline Miliary Dermatitis.
heavy crusting and itching
this case was eosinophilic dermatitis.



